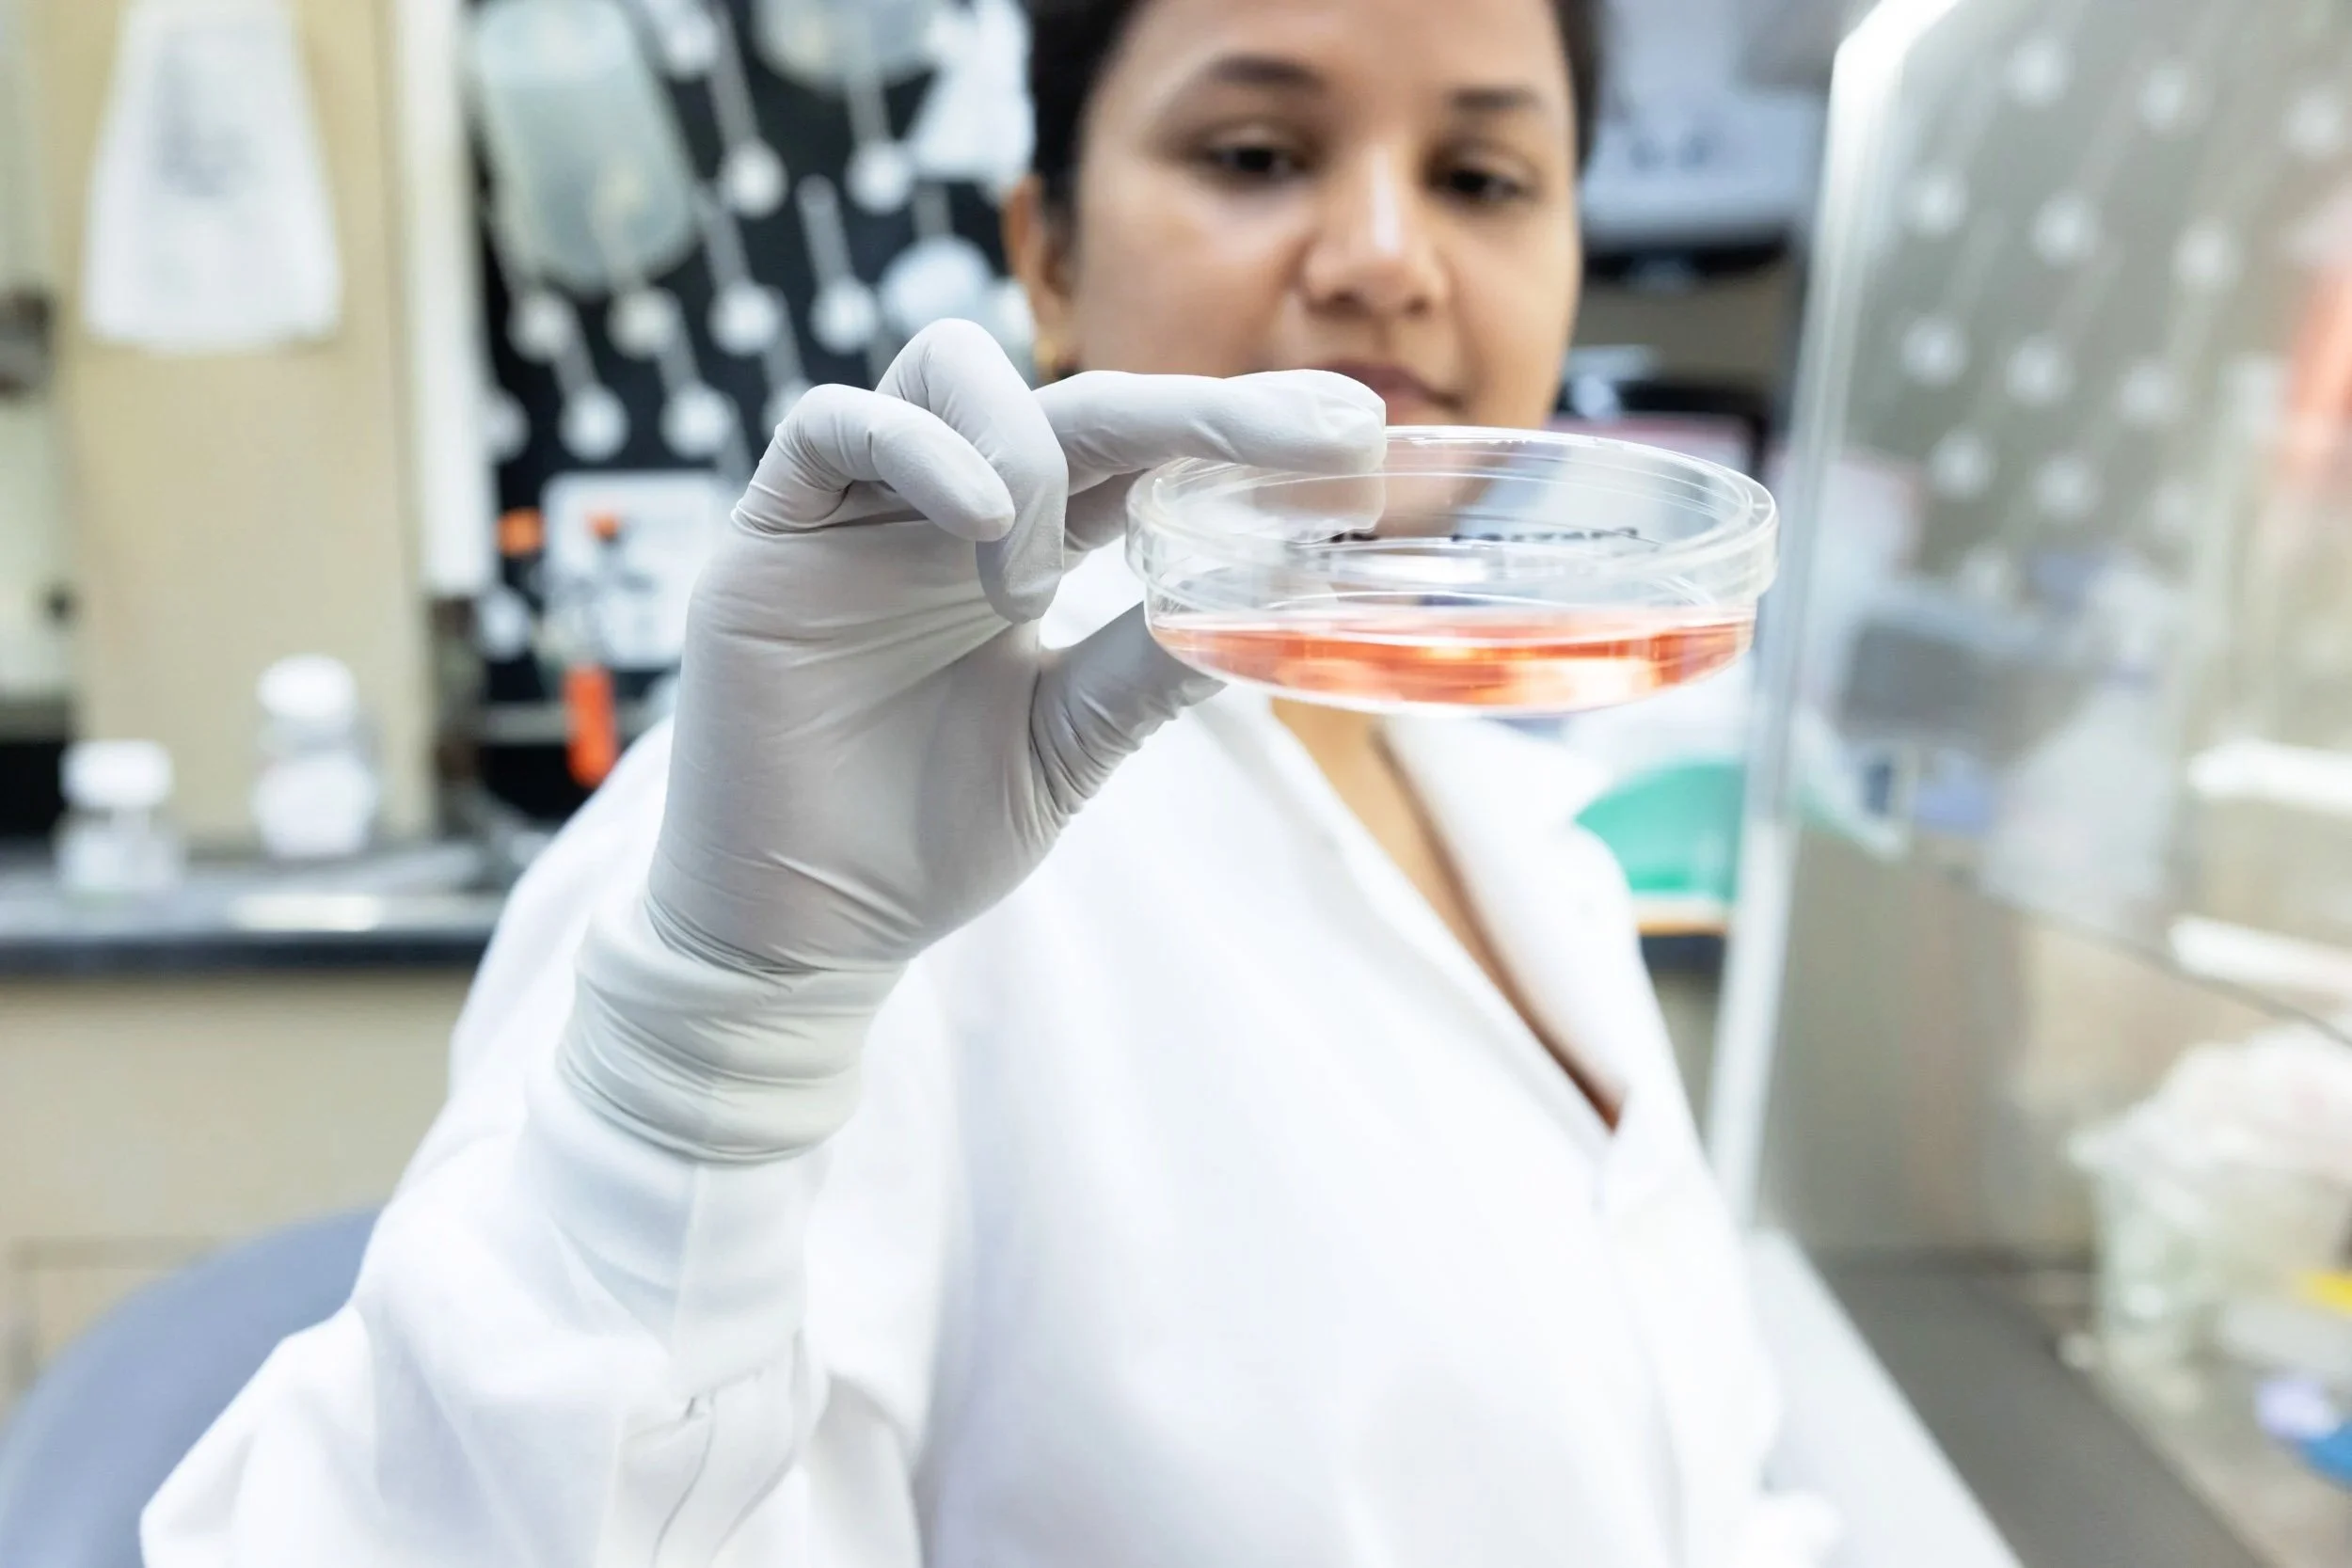
nonprofit-medical-research-documentation-petri-dish.jpg

Nonprofit Photographer in Connecticut, based in New Haven
Photography for mission-driven organizations, programs, and community initiatives across New Haven and Connecticut.
I work with nonprofit organizations to create thoughtful, respectful photography that documents people, programs, and impact. My work supports nonprofits through event photography, program documentation, leadership portraits, and storytelling imagery used for websites, fundraising, annual reports, and outreach. I also collaborate on projects connected to education photography and corporate photography when nonprofit work overlaps with schools, institutions, or organizational partners.
I’ve worked with nonprofit organizations of all sizes, from small community groups to established institutions, across education, healthcare, arts, and social services, and I also work with corporate organizations on projects that support mission-driven work.
Nonprofit Photography Services
I regularly photograph:
Nonprofit events including fundraisers, galas, community gatherings, and volunteer days
Programs and services that show your work in action
Leadership, staff, and board portraits for websites and publications
Environmental and contextual imagery that places your mission in its real setting
Facilities, campuses, and physical spaces, documenting the environments where nonprofit work happens, including offices, community spaces, and program sites.
Aerial and drone imagery, used selectively to provide context, scale, and a broader sense of place for campuses, developments, and community-focused projects, where permitted and appropriate.
My connection to nonprofit and community work is long-standing. I am the founder of I Love New Haven, a local photography initiative that has spent years documenting the people, organizations, and everyday work that shape the city. That experience informs how I approach nonprofit photography - with care, patience, and an understanding of trust.
I often work closely with communications teams, staff, and community partners to understand the goals behind each assignment, whether the images are intended for fundraising, reporting, marketing, or long-term documentation. This collaboration helps ensure the photographs support clear communication and reflect the organization’s values.
Nonprofit photography often involves sensitive work, real people, and stories that matter beyond a single moment. I approach every assignment with care for how individuals and organizations are represented, understanding that these images often live on long after an event or campaign has ended.
My goal is to create photographs that feel accurate, respectful, and genuinely useful - work shaped by the organization’s mission and intended audience. If you’re looking for photography that reflects your values with clarity and care, I’d be glad to talk about your goals.